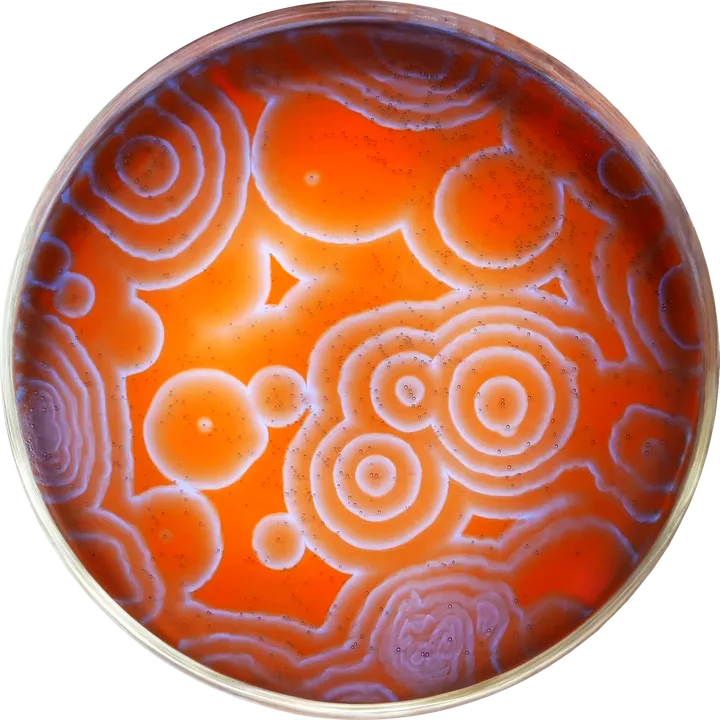
NileRed

Top 1,000 TikTok Influencers in Canada (Jun. 2026)
Explore the definitive list of Canada's most engaging TikTok creators. Streamline your campaign by connecting with local talent that resonates with Canadian audiences.
Identify Niche Canadian Creators with AI
Use our AI-powered search to filter by location and interest, finding the ideal Canadian TikTok partners in seconds.
Canada
79M Followers
1.8M Avg.Views
7.8% Engagement Rate
Canada
28.6M Followers
1.2M Avg.Views
14.9% Engagement Rate
Tired of Scrolling?
There is no need to search manually. Scrumball is the best platform to find, work with, and manage the perfect influencers for your brand campaigns.

Canada
24.4M Followers
621.3K Avg.Views
6.5% Engagement Rate
Canada
22.6M Followers
2.1M Avg.Views
15.5% Engagement Rate
Canada
15.9M Followers
696.1K Avg.Views
6.4% Engagement Rate
Canada
15.5M Followers
1.3M Avg.Views
11.1% Engagement Rate
Canada
13.9M Followers
60.9K Avg.Views
5.8% Engagement Rate
Canada
12.1M Followers
2M Avg.Views
3% Engagement Rate
Canada
11.2M Followers
47.7K Avg.Views
6% Engagement Rate
Canada
10.7M Followers
2.3M Avg.Views
11.7% Engagement Rate
Canada
10.1M Followers
1M Avg.Views
8.4% Engagement Rate
Canada
9.9M Followers
1.8K Avg.Views
3.5% Engagement Rate
Canada
9M Followers
1.1M Avg.Views
0.7% Engagement Rate
Canada
8.5M Followers
38.7K Avg.Views
29.3% Engagement Rate
Canada
8.5M Followers
99K Avg.Views
17.8% Engagement Rate
Canada
8.1M Followers
8.4M Avg.Views
13.2% Engagement Rate
Canada
7.6M Followers
1.1M Avg.Views
6.2% Engagement Rate
Canada
7.4M Followers
813.5K Avg.Views
15.6% Engagement Rate
Canada
7.4M Followers
165.4K Avg.Views
2.6% Engagement Rate
Canada
7.4M Followers
572.4K Avg.Views
11% Engagement Rate
Canada
7.4M Followers
4.2M Avg.Views
14.2% Engagement Rate
Canada
7.3M Followers
212.6K Avg.Views
3% Engagement Rate
Canada
7.3M Followers
24.3M Avg.Views
11.5% Engagement Rate
Canada
7.1M Followers
207.4K Avg.Views
19.7% Engagement Rate
Canada
6.9M Followers
1.3M Avg.Views
12.5% Engagement Rate
Canada
6.7M Followers
464.3K Avg.Views
2.2% Engagement Rate
Canada
6.6M Followers
501.6K Avg.Views
10.5% Engagement Rate
Canada
6.6M Followers
218.4K Avg.Views
7.8% Engagement Rate
Canada
6.5M Followers
58.8K Avg.Views
2.3% Engagement Rate
Canada
6.4M Followers
221.8K Avg.Views
10.7% Engagement Rate
Canada
6.3M Followers
1.5M Avg.Views
17.7% Engagement Rate
Canada
6.2M Followers
668.9K Avg.Views
6.9% Engagement Rate
Canada
6.2M Followers
516.6K Avg.Views
16.6% Engagement Rate
Canada
6.2M Followers
359K Avg.Views
4.1% Engagement Rate
Canada
6.2M Followers
185.7K Avg.Views
23.3% Engagement Rate
Canada
6.2M Followers
1.8M Avg.Views
9.1% Engagement Rate
Canada
6M Followers
215.8K Avg.Views
7.7% Engagement Rate
Canada
5.9M Followers
2M Avg.Views
3.3% Engagement Rate
Canada
5.8M Followers
1M Avg.Views
9.6% Engagement Rate
Canada
5.7M Followers
891.4K Avg.Views
23.1% Engagement Rate
Canada
5.6M Followers
14.4M Avg.Views
15.7% Engagement Rate
Canada
5.6M Followers
303.1K Avg.Views
4% Engagement Rate
Canada
5.5M Followers
3.2M Avg.Views
9.6% Engagement Rate
Canada
5.5M Followers
1.3M Avg.Views
5.5% Engagement Rate
Canada
5.4M Followers
1M Avg.Views
10.8% Engagement Rate
Canada
5.4M Followers
13.1M Avg.Views
22.7% Engagement Rate
Canada
5.3M Followers
190.5K Avg.Views
95.8% Engagement Rate
Canada
5.3M Followers
125.3K Avg.Views
7.2% Engagement Rate
Canada
5.2M Followers
650.7K Avg.Views
1% Engagement Rate
Canada
5.2M Followers
27K Avg.Views
13.2% Engagement Rate
Canada
4.9M Followers
91.7K Avg.Views
10.3% Engagement Rate
Canada
4.9M Followers
1.2M Avg.Views
12.8% Engagement Rate
Canada
4.8M Followers
614.6K Avg.Views
13.4% Engagement Rate
Canada
4.8M Followers
2.6M Avg.Views
12.8% Engagement Rate
Canada
4.8M Followers
154.1K Avg.Views
10.4% Engagement Rate
Canada
4.8M Followers
306.5K Avg.Views
11.5% Engagement Rate
Canada
4.7M Followers
1M Avg.Views
67.3% Engagement Rate
Canada
4.7M Followers
136.6K Avg.Views
8.6% Engagement Rate
Canada
4.6M Followers
4.9M Avg.Views
71.9% Engagement Rate
Canada
4.6M Followers
143K Avg.Views
5.2% Engagement Rate
Canada
4.5M Followers
480.3K Avg.Views
13.1% Engagement Rate
Canada
4.5M Followers
206.9K Avg.Views
5.2% Engagement Rate
Canada
4.4M Followers
9.6K Avg.Views
1.9% Engagement Rate
Canada
4.4M Followers
578.2K Avg.Views
5.5% Engagement Rate
Canada
4.4M Followers
3.1M Avg.Views
6.3% Engagement Rate
Canada
4.3M Followers
95K Avg.Views
53.2% Engagement Rate
Canada
4.3M Followers
465.8K Avg.Views
12.2% Engagement Rate
Common Questions About Canadian TikTok Marketing
Scale Your Presence in Canada
Sign up for free to access in-depth analytics on the top TikTok influencers across Canada.